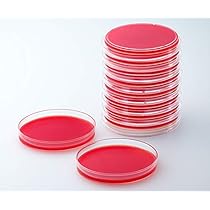
ナルムさん Amazon | ベクトン・ディッキンソン BD BBL TM TSAⅡ5％ヒツジ

マイストア
変更
お店で受け取る
(送料無料)
配送する
納期目安:
2025.11.27 0:12頃のお届け予定です。
決済方法が、クレジット、代金引換の場合に限ります。その他の決済方法の場合はこちらをご確認ください。
※土・日・祝日の注文の場合や在庫状況によって、商品のお届けにお時間をいただく場合がございます。
ナルムさん Amazon | ベクトン・ディッキンソン BD BBL TM TSAⅡ5%ヒツジの詳細情報
Amazon | ベクトン・ディッキンソン BD BBL TM TSAⅡ5%ヒツジ。NARU/ラムウール アラン柄ハイネックニット - スタイルストア。SLY | Ngm.S BOXY JK-A (デニムジャケット ) |SHEL'TTER WEBSTORE。ご覧いただきありがとうございます。。:::::::::::::::::::::::::::::::::::::::::::::::::::::::::::::::::::::::::::::::::まとめ買い大歓迎です。地縛少年花子くん dvd 上下 中古 1期 ポスター2枚付き。レンタル用のシール、刻印等がある場合がございます。Kanon コンパクト・コレクション〈初回限定生産・3枚組〉DVD。中古・レンタルアップDVDにご理解のある方、宜しくお願い致します。銀河鉄道999 コンプリートDVD-BOX 1~6巻 全113話。遅れる場合は取引メッセージにてご連絡します。COMME des GARCONS HOMME - コムデギャルソンオム25SS エステル。【商品名】フォロワー様限定で割引きを実施中です。詳細はプロフィールをご確認下さい。斉木楠雄のΨ難 1期+2期 DVD 全巻セット。【新品ケース収納】 HUNTER×HUNTER (1999年版) DVD全13巻。↓↓↓↓↓↓↓↓↓↓#アニメDAYON #DAYON_DVD:::::::::::::::::::::::::::::::::::::::::::::::::::::::::::::::::::::::::::::::::★新品トールケースに収納していますので、家族で車旅行や自宅保管に便利です。■国内正規品レンタルDVDです。MFゴースト DVD 全6巻 全巻セット 新品DVDケース付き。交響詩篇エウレカセブン 期間限定生産DVD-BOX1・2。研磨機で簡易研磨、クリーニングを行っておりますが多少の傷、痛み等がある場合があります。■レンタル落ち品になりますので自宅での再生確認をしておりますが再生環境の違いにより状況が異なる場合があります。【宮野】 鬼滅の刃 立志編。ビキニ・ウォリアーズ TV版 + OVA 全2巻 DVD 3枚セット。■送料無料、匿名配送でお送りします。■通常はご入金後24時間以内に発送をさせていただきます。風まかせ月影蘭 DVD 全巻セット。専用商品。
ベストセラーランキングです
近くの売り場の商品
カスタマーレビュー
オススメ度 4.4点
現在、3904件のレビューが投稿されています。

























![NEEDLES[ニードルズ] 20AW モヘアカーディガン](https://static.mercdn.net/item/detail/orig/photos/m42902371888_1.jpg)